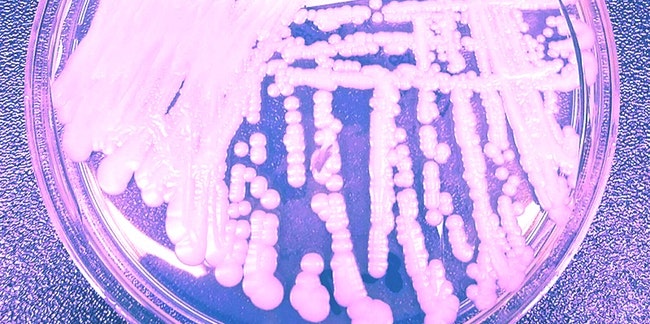

Here’s a little breaking news: Oscar nominations were announced this morning, and among the titles Inverse readers may be interested in were these noms:
- Star Wars: Rise of Skywalker (Original Score, Sound Mixing)
- Joker (Best Picture, Original Score, Costume, Sound Editing, Sound Mixing, Film Editing, Cinematography, Visual Effects, Makeup and Hairstyling, and Adapted Screenplay)
- Ad Astra (Sound Mixing)
- Parasite (Best Picture, International Feature Film, Production Design, Film Editing, Original Screenplay)
- Avengers: Endgame (Visual Effects)
And congratulations to Joaquin Phoenix (Leading Actor, for Joker) and Todd Phillips (Directing, for Joker) for their nominations. The 2020 Oscars are on February 9.
I’m Nick Lucchesi, executive editor at Inverse, and this is Inverse Daily, your essential source for the latest in science and technology.
This article is an adapted version of the Inverse Daily newsletter. Subscribe for free and earn rewards for reading every day.
INVERSE QUOTE OF THE DAY
“It is unknown why some people develop allergies in the first place.”
— Jamie Orengo, researcher at Regeneron Pharmaceuticals.

Do your bones store allergy memories?
When the immune system detects an invader — peanut butter, pollen, or another common allergen — it creates immunoglobulin E (IgE) antibodies that spur allergic reactions, from asthma to skin rashes. But exactly where and how these antibodies originate has been unclear. Now, researchers say they have pinpointed where IgE antibodies and their “allergy memories” are generated and stored. It turns out, the key to finding the source of allergies may lie in our bones.
Allergies are surging globally, likely because of rising pollution levels and reduced biodiversity. The new study could help these new allergy sufferers avoid going into potentially deadly anaphylactic shock.
Related stories:

The next big hospital superbug
In the early 2010s, a strange and life-threatening fungus emerged in far-flung corners of the globe. In 2009, it appeared in the ear of a patient in Japan. By 2013 and 2014, it was in Venezuela, India, South Africa, and Kuwait. By 2016, the fungus had moved to New York. In 2020, it’s now solidified its place as a “serious global health threat,” according to the CDC.
Scientists are particularly concerned because C. auris can develop the ability to resist three major classes of antibiotics, and it showed this dangerous capability in three separate patients described in a CDC report released last week.
Related stories:

An ancient stone describes a modern problem
The Rök Stone, an ancient, five-ton granite slab erected by Vikings in southern Sweden in the 9th century AD, has baffled scientists for more than 100 years. Its inscriptions are the earliest known example of written literature in Sweden, but unfortunately they are extremely well encrypted. But last week, codebreakers announced they may have finally cracked the case.
Swedish researchers have laid out a new interpretation of the Rök Stone, one that reveals an unexpected preoccupation for the Vikings who erected it. It’s a problem that’s on the minds of many today, too.
More viking history & science:

The secret to building lunar colonies
In recent years, 3D printing has come a long way — from tiny trinkets you see at maker faires to emailing tool designs to the ISS — but is the technology ready to print 3D habitats on the Moon?
A new study published last week introduces a new and improved way to manufacture metal alloys using 3D printers that would make them stronger than ever. The approach hinges on a clever use of ultrasonic vibrations that researchers used during the printing process to create a finer internal structure in the metals. This helped avoid previous splintering problems during manufacturing.
While the study itself doesn’t directly address lunar colonies, it does open up a potential pathway. As astronauts gear up to head back to the Moon in coming years as part of the Artemis program, this new manufacturing technique might be able to help them finally build their lunar homes.
Related stories:

You can still do a Dry January
For one in five Americans, now is the time of year to dry out. That’s how many people at least planned to participate in Dry January, or taking a month off drinking. But between social pressures and alcohol habits that die particularly hard, it’s easy for even the best-intentioned folks not to make it to the finish line.
Fortunately, using research-backed methods to curb your drinking can make it easier. Scientists and advocates say that talking about your intentions, tracking your progress, and establishing a support system will give you a boost toward completing the 31-day challenge.
Dry January has many positives, as research shows — like saving money and losing weight — plus, not waking up with a hangover is fantastic. To stay dry for the rest of the month and reap those benefits, take a look at what science suggests will make it stick.
More research on Dry January:
Meanwhile …
- Joker steals all 2020 Oscar nominations, but can it win?
- 5 actionable tips to drastically improve your gut health.
- ‘Realistic relationship goals’: Experts explain what it takes for love to last.
- Who is the hooded man on HBO’s The Outsider? Here are 3 theories.
- Mandalorian Season 2 set photos may solve a glaring Rise of Skywalker mystery.”
- New Kylo comic makes “High Republic” canon, fueling Star Wars movie rumors.
Inverse Loot
Subscribe to Inverse Loot and learn about these deals first.
That’s all for today!
Thank you for reading, and if you have a suggestion for how to make this newsletter better, drop me a line at nick@inverse.com. And follow me on Twitter, where I retweet the best of Inverse every day.







